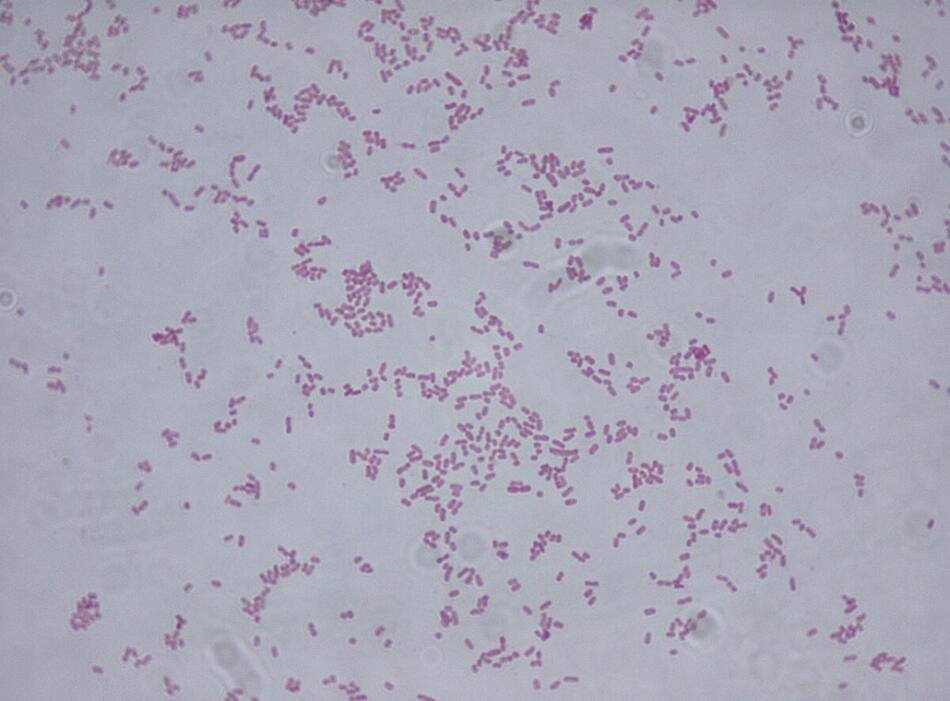

Murieron 13 niños en México y sospechan de la bacteria Klebsiella oxytoca

Al menos 13 niños murieron en México, posiblemente por la bacteria Klebsiella oxytoca, de la que se infectaron en hospitales, informó la Secretaría de Salud del Gobierno de México.
La dependencia federal estudió 20 casos, de los que cuatro continúan como probables y uno descartado, en pacientes de 0 a 14 años por posible contaminación de nutrición parenteral (NPT), es decir, alimentación ultravenosa, en tres hospitales públicos y una clínica privada.
"De los 20 casos, se registraron 13 defunciones de pacientes que poseían comorbilidades por lo que se encuentran en proceso de dictaminación para determinar si la causa de muerte está asociada a la ITS (infección) por Klebsiella oxytoca MDR. Asimismo, siete pacientes se encuentran hospitalizados", detalló en un comunicado.
Bacteria Klebsiella oxytoca.
También podría interesarte
Esta bacteria provoca infecciones urinarias o de vías biliares, y suele reportarse en hospitales y, en especial, en pacientes diabéticos, que han recibido antes antibióticos o con alguna enfermedad previa de gravedad.
Las investigaciones iniciales del Gobierno indican una posible contaminación en las soluciones de NPT de la empresa SAFE, pero no se descartan otras hipótesis, añadió el texto informativo.
Los análisis buscan identificar la fuente del brote y "se mantiene un monitoreo permanente para descartar posibles brotes en otras entidades", aseveró la dependencia.